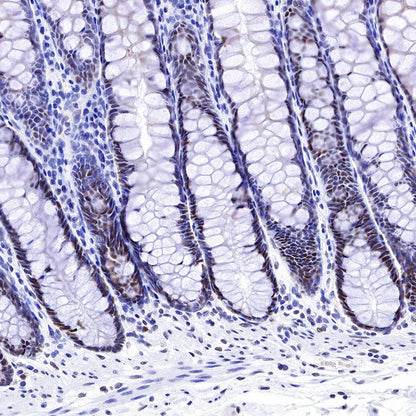
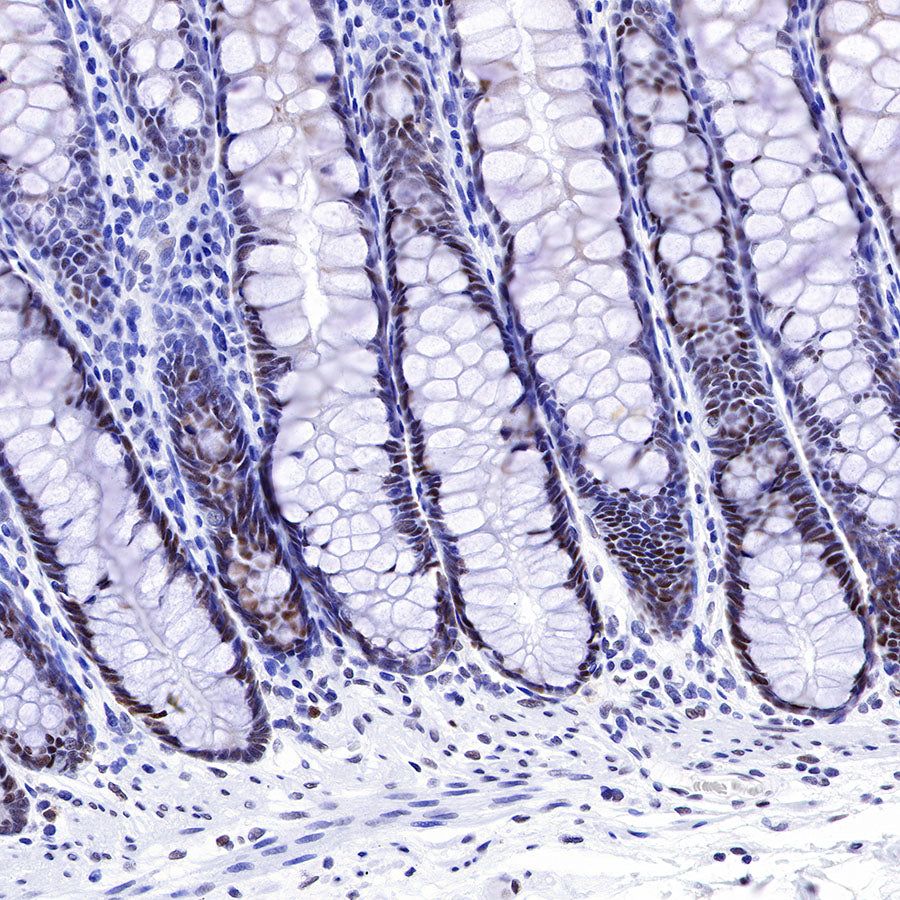

WB result of MSH2 Rabbit mAb
Primary antibody: MSH2 Rabbit mAb at 1/500 dilution
Lane 1: HeLa whole cell lysate 20 µg
Lane 2: HCT 116 whole cell lysate 20 µg
Lane 3: SW480 whole cell lysate 20 µg
Secondary antibody: Goat Anti-Rabbit IgG, (H+L), HRP conjugated at 1/10000 dilution
Predicted MW: 105 kDa
Observed MW: 105 kDa
Product Details
Product Details
Product Specification
| Host | Rabbit |
| Antigen | MSH2 |
| Synonyms | hMSH2, MutS protein homolog 2 |
| Immunogen | Synthetic Peptide |
| Location | Nucleus |
| Accession | P43246 |
| Clone Number | SDT-037-20 |
| Antibody Type | Rabbit mAb |
| Application | WB, IHC-P, ICC, ICFCM, IP |
| Reactivity | Hu |
| Predicted Reactivity | Pr |
| Purification | Protein A |
| Concentration | 0.25 mg/ml |
| Physical Appearance | Liquid |
| Storage Buffer | PBS, 40% Glycerol, 0.05% BSA, 0.03% Proclin 300 |
| Stability & Storage | 12 months from date of receipt / reconstitution, -20 °C as supplied |
Dilution
| application | dilution | species |
| IHC-P | 1:2000 | |
| WB | 1:500 | |
| ICFCM | 1:250 | |
| ICC | 1:250 | |
| IP | 1:25 |
Background
MSH2 is a key mammalian DNA mismatch repair (MMR) gene and mutations or deficiencies in mammalian Msh2 gene result in microsatellite instability (MSI+) and the development of cancer [PMID: 16331258]. Mismatch repair (MMR) proteins is a group of nuclear enzymes, which in all proliferating cells participate in repair of base-base mismatch, that occur during DNA replication. The proteins form complexes (heterodimers) that bind to areas of abnormal DNA and initiates its removal. Loss of MMR proteins leads to an accumulation of DNA replication errors in the proliferating cells, particularly in areas of the genome with short repetitive nucleotide sequences, a phenomenon known as microsatellite instability (MSI). In human, nine genes with MMR function have been identified. More than 300 different mutations have been identified. Persons carrying a mutation have normal MMR proteins, but in case of a DNA damage involving the nonmutated allel, the protein production stops (loss of heterozygosity). When forming complexes MLH1 heterodimerizes with PMS2, PMS1 or MLH3 (another MMR protein, for which a mutation has not been detected), while MSH2 heterodimerizes with MSH6. In case of MSH2 deficiency, MSH6 protein is also lost, possibly because of protein instability.
Picture
Picture
Western Blot

FC

Flow cytometric analysis of 4% PFA fixed 90% methanol permeabilized HeLa (Human cervix adenocarcinoma epithelial cell) cells labelling MSH2 antibody at 1/250 (0.1 μg) dilution / (red) compared with a Rabbit monoclonal IgG (Black) isotype control and an unlabelled control (cells without incubation with primary antibody and secondary antibody) (Blue). Goat Anti - Rabbit IgG Alexa Fluor® 488 was used as the secondary antibody.
IP

MSH2 Rabbit mAb at 1/25 dilution (1µg) immunoprecipitating MSH2 in 0.4mg HeLa whole cell lysate.
Western blot was performed on the immunoprecipitate using MSH2 Rabbit mAb at 1/1000 dilution.
Secondary antibody (HRP) for IP was used at 1/400 dilution.
Lane 1 : HeLa whole cell lysate 10µg(input)
Lane 2 : MSH2 Rabbit mAb IP in HeLa whole cell lysate
Lane 3 : Rabbit monoclonal IgG IP in HeLa whole cell lysate
Predicted MW: 105 kDa
Observed MW: 105 kDa
Immunohistochemistry

IHC shows positive staining in paraffin-embedded human tonsil. Anti-MSH2 antibody was used at 1/2000 dilution, followed by a HRP Polymer for Mouse & Rabbit IgG (ready to use). Counterstained with hematoxylin. Heat mediated antigen retrieval with Tris/EDTA buffer pH9.0 was performed before commencing with IHC staining protocol.

IHC shows positive staining in paraffin-embedded human colon. Anti-MSH2 antibody was used at 1/2000 dilution, followed by a HRP Polymer for Mouse & Rabbit IgG (ready to use). Counterstained with hematoxylin. Heat mediated antigen retrieval with Tris/EDTA buffer pH9.0 was performed before commencing with IHC staining protocol.

IHC shows positive staining in paraffin-embedded human colon cancer (Loss of MSH2 expression in tumors but nuclear expression in paracancerous cells). Anti-MSH2 antibody was used at 1/2000 dilution, followed by a HRP Polymer for Mouse & Rabbit IgG (ready to use). Counterstained with hematoxylin. Heat mediated antigen retrieval with Tris/EDTA buffer pH9.0 was performed before commencing with IHC staining protocol.

IHC shows positive staining in paraffin-embedded human colon cancer (Loss of MSH2 expression in individual tumor cells). Anti-MSH2 antibody was used at 1/2000 dilution, followed by a HRP Polymer for Mouse & Rabbit IgG (ready to use). Counterstained with hematoxylin. Heat mediated antigen retrieval with Tris/EDTA buffer pH9.0 was performed before commencing with IHC staining protocol.

IHC shows positive staining in paraffin-embedded human endometrial cancer. Anti-MSH2 antibody was used at 1/2000 dilution, followed by a HRP Polymer for Mouse & Rabbit IgG (ready to use). Counterstained with hematoxylin. Heat mediated antigen retrieval with Tris/EDTA buffer pH9.0 was performed before commencing with IHC staining protocol.
Immunocytochemistry

ICC shows positive staining in HeLa cells. Anti-MSH2 antibody was used at 1/250 dilution (Green) and incubated overnight at 4°C. Goat polyclonal Antibody to Rabbit IgG - H&L (Alexa Fluor® 488) was used as secondary antibody at 1/1000 dilution. The cells were fixed with 100% ice-cold methanol and permeabilized with 0.1% PBS-Triton X-100. Nuclei were counterstained with DAPI (Blue). Counterstain with tubulin (red).